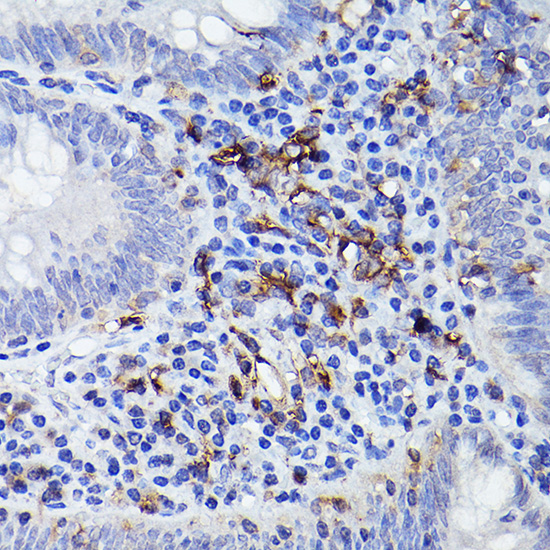

Product Name :
HLA-DQB1 polyclonal antibody Background :
HLA-DQB1 belongs to the HLA class II beta chain paralogs. This class II molecule is a heterodimer consisting of an alpha (DQA) and a beta chain (DQB), both anchored in the membrane. It plays a central role in the immune system by presenting peptides derived from extracellular proteins. Class II molecules are expressed in antigen presenting cells (APC: B lymphocytes, dendritic cells, macrophages). The beta chain is approximately 26-28 kDa and it contains six exons. Exon 1 encodes the leader peptide, exons 2 and 3 encode the two extracellular domains, exon 4 encodes the transmembrane domain and exon 5 encodes the cytoplasmic tail. Within the DQ molecule both the alpha chain and the beta chain contain the polymorphisms specifying the peptide binding specificities, resulting in up to four different molecules. Typing for these polymorphisms is routinely done for bone marrow transplantation. Alternative splicing results in multiple transcript variants. Product :
1mg/ml in PBS with 0.02% sodium azide, 50% glycerol, pH7.2 Storage&Stability :
Store at 4°C short term. Aliquot and store at -20°C long term. Avoid freeze-thaw cycles. Specificity :
Unmodification Immunogen :
Recombinant fusion protein of human HLA-DQB1(NP_002114.3). Conjugate :
Unconjugated Modification :
Unmodification
HLA-DQB1 polyclonal antibody Background :
HLA-DQB1 belongs to the HLA class II beta chain paralogs. This class II molecule is a heterodimer consisting of an alpha (DQA) and a beta chain (DQB), both anchored in the membrane. It plays a central role in the immune system by presenting peptides derived from extracellular proteins. Class II molecules are expressed in antigen presenting cells (APC: B lymphocytes, dendritic cells, macrophages). The beta chain is approximately 26-28 kDa and it contains six exons. Exon 1 encodes the leader peptide, exons 2 and 3 encode the two extracellular domains, exon 4 encodes the transmembrane domain and exon 5 encodes the cytoplasmic tail. Within the DQ molecule both the alpha chain and the beta chain contain the polymorphisms specifying the peptide binding specificities, resulting in up to four different molecules. Typing for these polymorphisms is routinely done for bone marrow transplantation. Alternative splicing results in multiple transcript variants. Product :
1mg/ml in PBS with 0.02% sodium azide, 50% glycerol, pH7.2 Storage&Stability :
Store at 4°C short term. Aliquot and store at -20°C long term. Avoid freeze-thaw cycles. Specificity :
Unmodification Immunogen :
Recombinant fusion protein of human HLA-DQB1(NP_002114.3). Conjugate :
Unconjugated Modification :
Unmodification
-
 Western blot analysis of extracts of Raji cells, using HLA-DQB1 antibody at 1:1000 dilution.
Western blot analysis of extracts of Raji cells, using HLA-DQB1 antibody at 1:1000 dilution.
Secondary antibody: HRP Goat Anti-Rabbit IgG at 1:10000 dilution.
Lysates/proteins: 25ug per lane.
Blocking buffer: 3% nonfat dry milk in TBST.
Detection: ECL Basic Kit .
Exposure time: 1s. -
 Immunohistochemistry of paraffin-embedded human tonsil using HLA-DQB1 antibody at dilution of 1:100 .Perform high pressure antigen retrieval with 10 mM citrate buffer pH 6.0 before commencing with IHC staining protocol.
Immunohistochemistry of paraffin-embedded human tonsil using HLA-DQB1 antibody at dilution of 1:100 .Perform high pressure antigen retrieval with 10 mM citrate buffer pH 6.0 before commencing with IHC staining protocol. -
Immunohistochemistry of paraffin-embedded human tonsil using HLA-DQB1 antibody at dilution of 1:100 .Perform high pressure antigen retrieval with 10 mM citrate buffer pH 6.0 before commencing with IHC staining protocol.
Immunohistochemistry of paraffin-embedded human tonsil using HLA-DQB1 antibody at dilution of 1:100 .Perform high pressure antigen retrieval with 10 mM citrate buffer pH 6.0 before commencing with IHC staining protocol.
Bioworld Biotech only provide peptides for our antibodies and do not provide additional peptide customization services.
Price/Size :
USD 368/1mg/vial
Tips:
For phospho antibody, we provide phospho peptide(0.5mg) and non-phospho peptide(0.5mg).Describe :
Blocking peptides are peptides that bind specifically to the target antibody and block antibody binding. These peptide usually contains the epitope recognized by the antibody. Antibodies bound to the blocking peptide no longer bind to the epitope on the target protein. This mechanism is useful when non-specific binding is an issue, for example, in Western blotting (WB) and Immunohistochemistry (IHC). By comparing the staining from the blocked antibody versus the antibody alone, one can see which staining is specific; Specific binding will be absent from the western blot or IHC performed with the neutralized antibody.Formula:
Synthetic peptide was lyophilized with 100% acetonitrile and is supplied as a powder. Reconstitute with 0.1 ml DI water for a final concentration of 10 mg/ml.The purity is >90%,tested by HPLC and MS.
Storage:
The freeze-dried powder is more stable. For short time at 2-8°C. For long term storage store at -20°C.
Note :
This product is for research use only (RUO only). Not for use in diagnostic or therapeutic procedures.
 HLA-DQB1 polyclonal antibody
HLA-DQB1 polyclonal antibody  Datasheet
Datasheet COA
COA MSDS
MSDS SHIP
SHIP